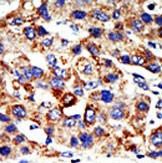
HDAC8 Antibody in Immunohistochemistry (Paraffin) (IHC (P))

Search
Invitrogen
HDAC8 Polyclonal Antibody
{{$productOrderCtrl.translations['antibody.pdp.commerceCard.promotion.promotions']}}
{{$productOrderCtrl.translations['antibody.pdp.commerceCard.promotion.viewpromo']}}
{{$productOrderCtrl.translations['antibody.pdp.commerceCard.promotion.promocode']}}: {{promo.promoCode}} {{promo.promoTitle}} {{promo.promoDescription}}. {{$productOrderCtrl.translations['antibody.pdp.commerceCard.promotion.learnmore']}}
图: 1 / 2
HDAC8 Antibody (PA5-11243) in IHC (P)


Please note: We are reviewing Western blot images included in the antibody testing data in our catalog, including those provided by third parties. Unless expressly labeled or annotated as “raw-unedited”, Western blot images included in the antibody testing data in our catalog may have been edited, optimized or otherwise adjusted for presentation.
产品信息
PA5-11243
种属反应
宿主/亚型
分类
类型
抗原
偶联物
形式
浓度
规格
纯化类型
保存液
内含物
保存条件
运输条件
RRID
靶标信息
In the intact cell, DNA closely associates with histones and other nuclear proteins to form chromatin. The remodeling of chromatin is believed to be a critical component of transcriptional regulation and a major source of this remodeling is brought about by the acetylation of nucleosomal histones. Acetylation of lysine residues in the amino terminal tail domain of histone results in an allosteric change in the nucleosomal conformation and an increased accessibility to transcription factors by DNA. Conversely, the deacetylation of histones is associated with transcriptional silencing. Several mammalian proteins have been identified as nuclear histone acetylases, including GCN5, PCAF (p300/CBP-associated factor), p300/CBP, HAT1 and the TFIID subunit TAF II p250. Mammalian HDAC8, isolated from human kidney, is a histone deacetylase that shares homology to other HDACs but has different tissue distribution. HDAC8 is localized to the nucleus and plays a role in the development of a broad range of tissues and in the etiology of cancer.
仅用于科研。不用于诊断过程。未经明确授权不得转售。
篇参考文献 (0)
生物信息学
蛋白别名: HD8; Histone deacetylase 8; Protein deacetylase HDAC8; Protein decrotonylase HDAC8
基因别名: CDA07; HDAC8; HDACL1
Entrez Gene ID: (Human) 55869